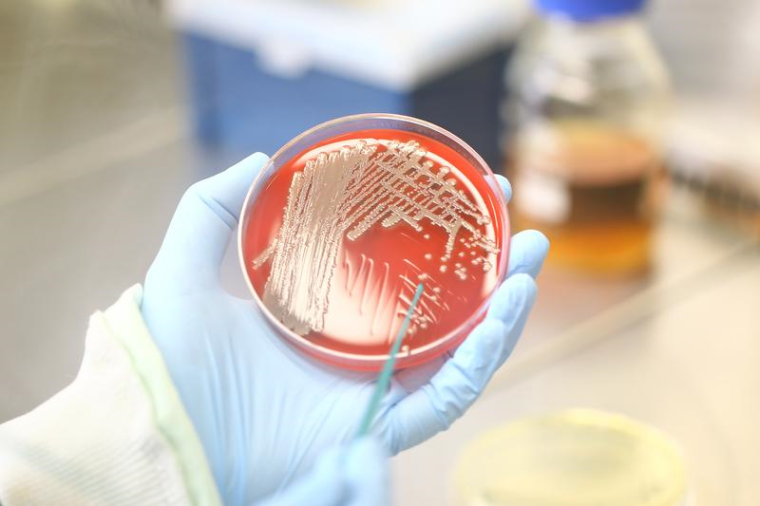
Staphylokokken-Kolonien auf bluthaltigem Nährboden. Foto: InfectoGnostics /...

Evolution und Verbreitungswege eines speziellen MRSA-Stammes
Ein MRSA-Superkeim vom indischen Subkontinent vereint die Eigenschaften von klinisch und ambulant erworbenen Erregern.
Ein internationales Forscherteam hat erstmals die Evolution und Verbreitungswege eines speziellen Stammes von Methicillin-resistenten Staphylococcus aureus (MRSA) im Detail analysiert. Der „Bengal Bay“-Klon vereint eine besondere Virulenz und das Potential zur weltweiten Ausbreitung mit der Multiresistenz von Krankenhauskeimen. Für die aufwendige Analyse arbeiteten 38 Wissenschaftler aus 15 Ländern über 8 Jahre zusammen. InfectoGnostics-Forscher des Leibniz-Instituts für Photonische Technologien (Leibniz-IPHT) und von Abbott (Alere Technologies) in Jena waren maßgeblich an der Analyse der Gensequenzen beteiligt.
Ursprünglich handelte es sich um einen recht seltenen und wenig bekannten MRSA-Stamm, den englische Infektiologen vor etwa 15 Jahren bei Patienten entdeckten, die in die Region am Golf von Bengalen gereist waren. Doch weitere Nachweise in verschiedenen Teilen der Welt und die besonderen Eigenschaften des Bengal-Bay-Klons weckten die Aufmerksamkeit von immer mehr Forschern: Dieses Bakterium tauchte meist außerhalb von Kliniken auf, zeigte aber viele Antibiotikaresistenzen, wie sie eigentlich nur von typischen Krankenhauserregern bekannt waren. Zudem wurde es immer häufiger auch in anderen Ländern nachgewiesen. Bei einem Kongress in Lyon im Sommer 2012 beschlossen deshalb einige Wissenschaftler aus verschiedenen Ländern, Isolate dieses MRSA-Klons zu sammeln und deren Genome zu analysieren. Gemeinsam setzten sie sich das Ziel, die Evolution und Verbreitungswege des besonderen Stamms zu verstehen.
Virtuelle Mikroarray-Analysen
Für die Untersuchung wurden in 14 Ländern 340 Isolate des Bengal-Bay-Klons gesammelt und anschließend mittels vollständiger Genomsequenzierung analysiert. Weitere experimentelle Daten zu Biofilm-Bildung, Wachstum und Toxizität wurden ebenfalls erhoben. Die Jenaer InfectoGnostics-Forscher aus der Gruppe von Prof. Ralf Ehricht (Leibniz-IPHT) führten hierfür virtuelle Mikroarray-Analysen zu den Daten der isolierten Stämme durch, was Auswertung und Interpretation der Genomsequenzen deutlich vereinfachte. Am Ende der jahrelangen Forschungsarbeit wurden die Ergebnisse aller 38 beteiligten Wissenschaftler wie in einem Puzzle zusammengefügt, um die stammesgeschichtliche Entwicklung des Bakteriums nachzuzeichnen.
Diese nun abgeschlossene Analyse der Genome hunderter repräsentativer Isolate des Stamms zeigt, dass auch durchsetzungsfähige, virulente MRSA-Stämme außerhalb der Klinik zahlreiche Resistenzgene in ihr Erbgut aufnehmen – ein Verhalten, das sonst eher typisch für Krankenhauskeime ist. „Wir konnten mit der aktuellen Analyse zeigen, dass Vorläufer des Bengal-Bay-Klons schon seit den 60er-Jahren in Indien und Bangladesch existieren. Das Bakterium hat in den letzten 30 Jahren schrittweise mobile genetische Elemente wie Plasmide und Gen-Kassetten in sein eigenes Genom integriert und sich so eine ganze Reihe an Resistenzmechanismen angeeignet. Bislang ist kein derart multiresistenter Stamm bekannt, der sich außerhalb von Krankenhäusern so weit verbreiten konnte und außerdem so viele Virulenzfaktoren trägt“, erläutert Dr. Stefan Monecke vom Leibniz-IPHT, der an den Mikroarray-Analysen in Jena beteiligt war.
Regulierte Antibiotikavergabe nötig
Ein solcher Stamm stellt nach Einschätzung von Dr. Monecke ein Problem gerade für ressourcenärmere Länder dar, die die Hauptlast des Ausbruchs tragen: „Außerhalb der Klinik wurden MRSA-Stämme zuvor meist durch virulentere, aber gegenüber Antibiotika empfindlichere, konkurrierende Stämme verdrängt. Unsere Ergebnisse zeigen hingegen, dass Bakterien, die außerhalb des Klinikumfelds in der gesunden Bevölkerung kursieren, durchaus ein mit Krankenhauskeimen vergleichbares Resistenzprofil erwerben können, ohne dass ihre Virulenz und ihre Fähigkeit zur Verbreitung davon beeinträchtigt wird.“ Die Entstehung eines solchen Bakterienstamms sei vor allem durch die unkontrollierte Antibiotikavergabe und soziale Faktoren, wie die hohe Bevölkerungsdichte bei schlechten Lebensbedingungen, begünstigt worden.
Eine vollständige und vergleichende Genomanalyse über mehr als ein Dutzend Länder sei zwar sehr aufwendig, doch, so Dr. Monecke weiter, „derartige internationalen Kollaborationen sind zwingend notwendig, um ein globales Problem wie das der Antibiotikaresistenzen wirklich zu verstehen und frühzeitig Präventionsmaßnahmen zu treffen. Unsere Ergebnisse zeigen: Wir benötigen schnellstens eine verbesserte Diagnostik – zum Beispiel günstige Schnelltests zum Nachweis von MRSA und deren Virulenzfaktoren – und eine strengere Regulierung des Gebrauchs von Antibiotika.“









